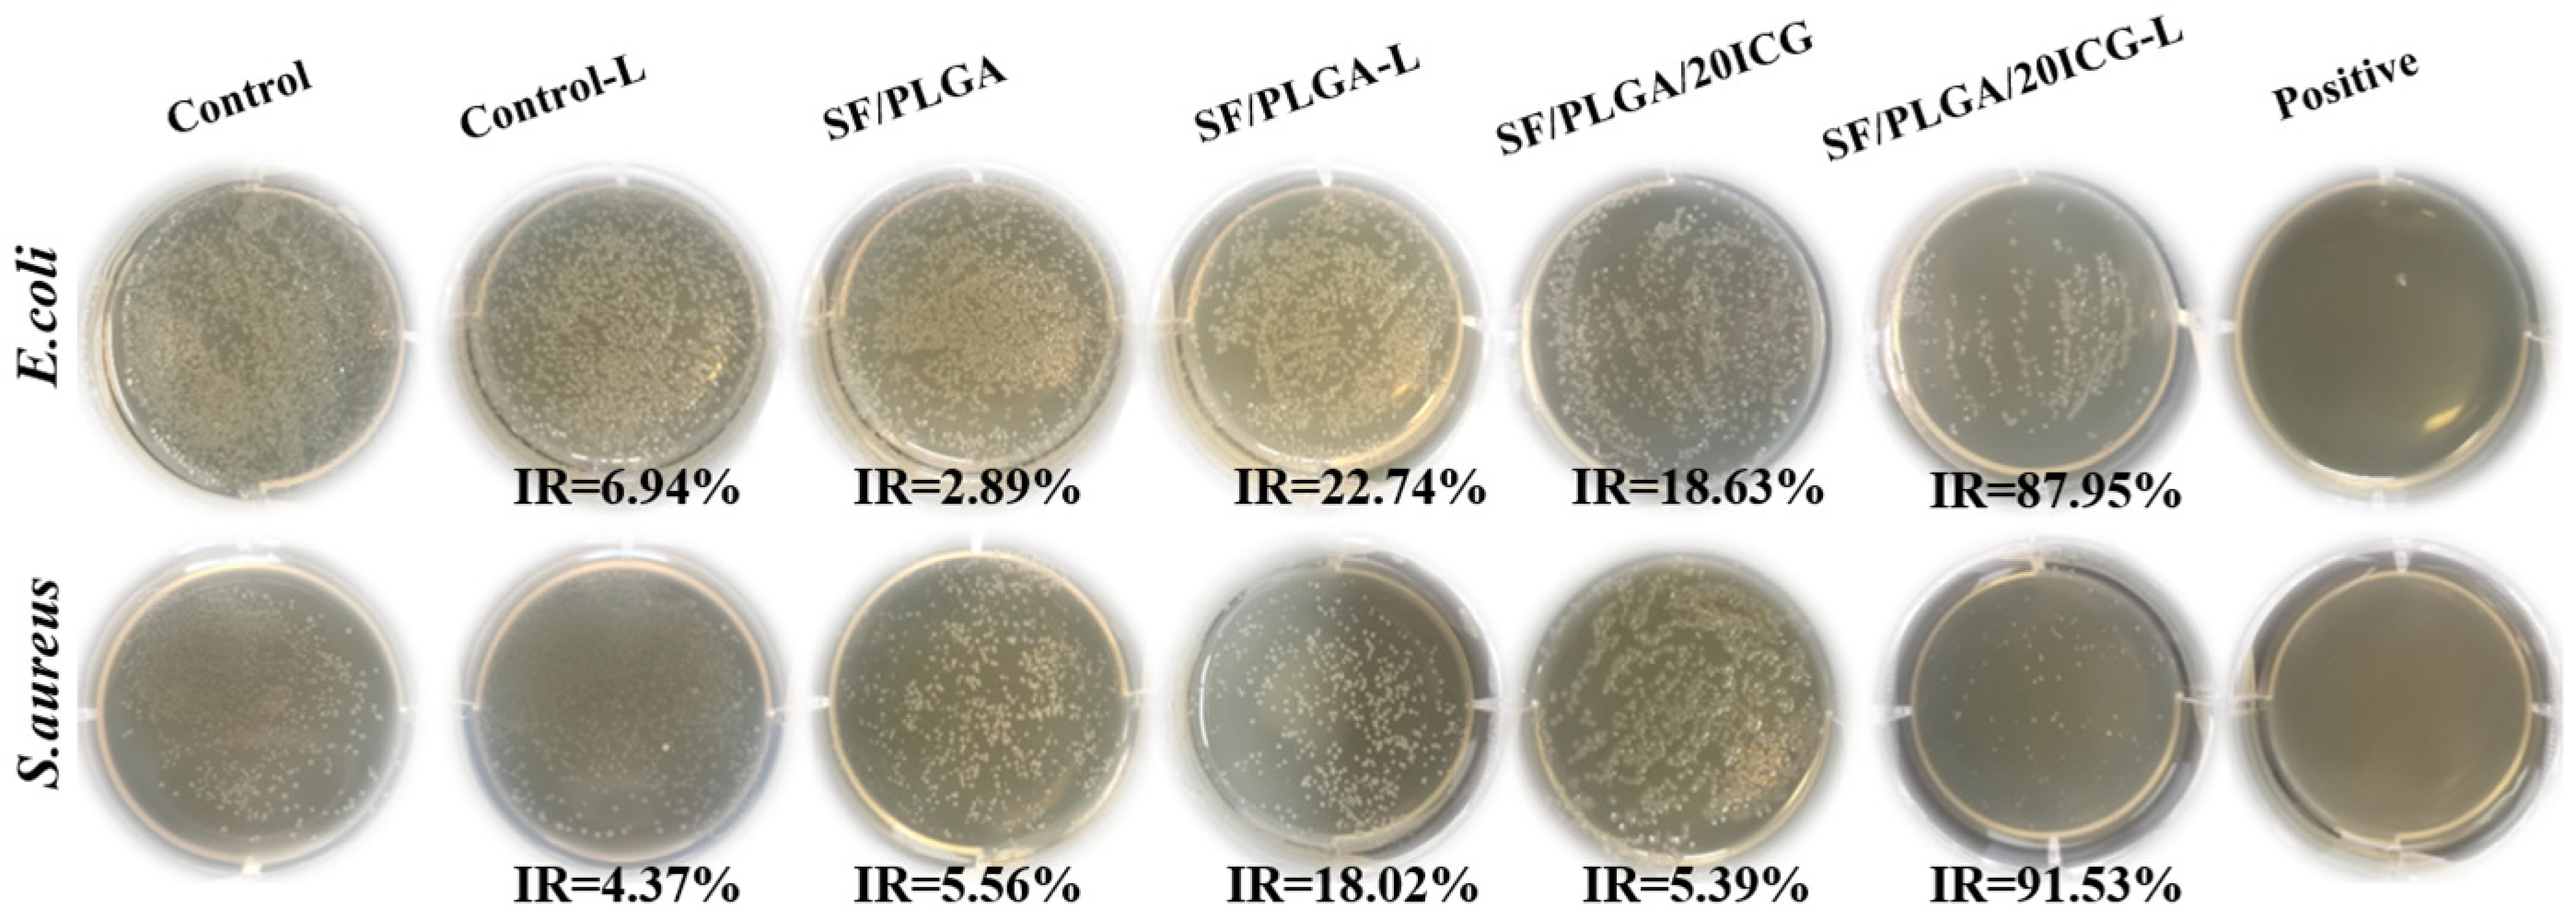
Processes 10 00850 g005 550

Electrospun SF/PLGA/ICG Composite Nanofibrous Membranes for Potential Wound Healing and Tumor Therapy
Abstract
:1. Introduction
2. Materials and Methods
2.1. Materials
2.2. Preparation of Nanofibrous Membranes Loaded with ICG
2.3. Characterization of the Nanofibrous Membranes
2.4. Biodegradability of Nanofibrous Membranes
2.5. In Vitro Release of ICG
2.6. Antimicrobial Activity of the Nanofibrous Membranes
2.7. In Vitro Cytocompatibility of the Nanofibrous Membranes
2.8. In Vitro Anti-Tumor Efficacy
3. Results and Discussion
3.1. Characterization of the ICG-Loaded Nanofibrous Membranes
3.2. In Vitro Release of ICG from the Nanofibrous Membranes
3.3. Photothermal Performance of the Nanofibrous Membranes
3.4. Antimicrobial Performance of the Nanofibrous Membranes Loaded with ICG
3.5. Biocompatibility of the Nanofibrous Membranes
3.6. In Vitro Antitumor Efficacy
4. Conclusions
Author Contributions
Funding
Institutional Review Board Statement
Informed Consent Statement
Data Availability Statement
Conflicts of Interest
References
- Hu, H.; Chen, J.T.; Yang, H.; Huang, X.T.; Wu, H.L.; Wu, Y.X.; Li, F.F.; Yi, Y.F.; Xiao, C.; Li, Y.H.; et al. Potentiating photodynamic therapy of ICG-loaded nanoparticles by depleting GSH with PEITC. Nanoscale 2019, 11, 6384–6393. [Google Scholar] [CrossRef] [PubMed]
- Spring, B.Q.; Rizvi, I.; Xu, N.; Hasan, T. The role of photodynamic therapy in overcoming cancer drug resistance. Photochem. Photobiol. Sci. 2015, 14, 1476–1491. [Google Scholar] [CrossRef] [PubMed] [Green Version]
- Xia, D.L.; Xu, P.P.; Luo, X.Y.; Zhu, J.F.; Gu, H.Y.; Huo, D.; Hu, Y. Overcoming Hypoxia by Multistage Nanoparticle Delivery System to Inhibit Mitochondrial Respiration for Photodynamic Therapy. Adv. Funct. Mater. 2019, 29, 1807294. [Google Scholar] [CrossRef]
- Wainwright, M. ‘Safe’ photoantimicrobials for skin and soft-tissue infections. Int. J. Antimicrob. Agents 2010, 36, 14–18. [Google Scholar] [CrossRef] [PubMed] [Green Version]
- Fu, X.J.; Fang, Y.; Yao, M. Antimicrobial Photodynamic Therapy for Methicillin-Resistant Staphylococcus aureus Infection. BioMed Res. Int. 2013, 2013, 159157. [Google Scholar] [CrossRef] [PubMed] [Green Version]
- Sperandio, F.F.; Huang, Y.Y.; Hamblin, M.R. Antimicrobial Photodynamic Therapy to Kill Gram-negative Bacteria. Recent Pat. Anti-Infect. Drug Discov. 2013, 8, 108–120. [Google Scholar] [CrossRef] [PubMed] [Green Version]
- Chen, Q.; Xu, L.G.; Liang, C.; Wang, C.; Peng, R.; Liu, Z. Photothermal therapy with immune-adjuvant nanoparticles together with checkpoint blockade for effective cancer immunotherapy. Nat. Commun. 2016, 7, 13193. [Google Scholar] [CrossRef]
- Bhattarai, P.; Dai, Z.F. Cyanine based Nanoprobes for Cancer Theranostics. Adv. Healthc. Mater. 2017, 6, 1700262. [Google Scholar] [CrossRef] [PubMed]
- Gholibegloo, E.; Karbasi, A.; Pourhajibagher, M.; Chiniforush, N.; Ramazani, A.; Akbari, T.; Bahador, A.; Khoobi, M. Carnosine-graphene oxide conjugates decorated with hydroxyapatite as promising nanocarrier for ICG loading with enhanced antibacterial effects in photodynamic therapy against Streptococcus mutans. J. Photochem. Photobiol. B Biol. 2018, 181, 14–22. [Google Scholar] [CrossRef] [PubMed]
- Sheng, Z.H.; Hu, D.H.; Xue, M.M.; He, M.; Gong, P.; Cai, L.T. Indocyanine Green Nanoparticles for Theranostic Applications. Nano-Micro Lett. 2013, 5, 145–150. [Google Scholar] [CrossRef]
- Zhang, C.L.; Yu, S.H. Nanoparticles meet electrospinning: Recent advances and future prospects. Chem. Soc. Rev. 2014, 43, 4423–4448. [Google Scholar] [CrossRef] [PubMed]
- Boudriot, U.; Dersch, R.; Greiner, A.; Wendorff, J.H. Electrospinning approaches toward scaffold engineering—A brief overview. Artif. Organs 2006, 30, 785–792. [Google Scholar] [CrossRef] [PubMed]
- Grund, S.; Bauer, M.; Fischer, D. Polymers in Drug Delivery-State of the Art and Future Trends. Adv. Eng. Mater. 2011, 13, B61–B87. [Google Scholar] [CrossRef]
- Chou, S.F.; Carson, D.; Woodrow, K.A. Current strategies for sustaining drug release from electrospun nanofibers. J. Control. Release 2015, 220, 584–591. [Google Scholar] [CrossRef] [Green Version]
- Agarwal, S.; Wendorff, J.H.; Greiner, A. Use of electrospinning technique for biomedical applications. Polymer 2008, 49, 5603–5621. [Google Scholar] [CrossRef] [Green Version]
- Sridhar, R.; Lakshminarayanan, R.; Madhaiyan, K.; Barathi, V.A.; Limh, K.H.C.; Ramakrishna, S. Electrosprayed nanoparticles and electrospun nanofibers based on natural materials: Applications in tissue regeneration, drug delivery and pharmaceuticals. Chem. Soc. Rev. 2015, 44, 790–814. [Google Scholar] [CrossRef] [PubMed] [Green Version]
- Preis, E.; Anders, T.; Sirc, J.; Hobzova, R.; Cocarta, A.I.; Bakowsky, U.; Jedelska, J. Biocompatible indocyanine green loaded PLA nanofibers for in situ antimicrobial photodynamic therapy. Mater. Sci. Eng. C Mater. Biol. Appl. 2020, 115, 111068. [Google Scholar] [CrossRef] [PubMed]
- Martins, C.; Sousa, F.; Araujo, F.; Sarmento, B. Functionalizing PLGA and PLGA Derivatives for Drug Delivery and Tissue Regeneration Applications. Adv. Healthc. Mater. 2018, 7, 1701035. [Google Scholar] [CrossRef]
- Hsu, M.Y.; Hsieh, C.H.; Huang, Y.T.; Chu, S.Y.; Chen, C.M.; Lee, W.J.; Liu, S.J. Enhanced Paclitaxel Efficacy to Suppress Triple-Negative Breast Cancer Progression Using Metronomic Chemotherapy with a Controlled Release System of Electrospun Poly-d-l-Lactide-Co-Glycolide (PLGA) Nanofibers. Cancers 2021, 13, 3350. [Google Scholar] [CrossRef] [PubMed]
- Saxena, V.; Sadoqi, M.; Shao, J. Enhanced photo-stability, thermal-stability and aqueous-stability of indocyanine green in polymeric nanoparticulate systems. J. Photochem. Photobiol. B-Biol. 2004, 74, 29–38. [Google Scholar] [CrossRef] [PubMed]
- Tsang, V.L.; Bhatia, S.N. Three-dimensional tissue fabrication. Adv. Drug Deliv. Rev. 2004, 56, 1635–1647. [Google Scholar] [CrossRef]
- Bai, S.; Liu, S.; Zhang, C.; Xu, W.; Lu, Q.; Han, H.; Kaplan, D.L.; Zhu, H. Controllable transition of silk fibroin nanostructures: An insight into in vitro silk self-assembly process. Acta Biomater. 2013, 9, 7806–7813. [Google Scholar] [CrossRef]
- Siskova, A.O.; Kozma, E.; Opalek, A.; Kronekova, Z.; Kleinova, A.; Nagy, T.; Kronek, J.; Rydz, J.; Andicsova, A.E. Diclofenac Embedded in Silk Fibroin Fibers as a Drug Delivery System. Materials 2020, 13, 3580. [Google Scholar] [CrossRef]
- Peng, Y.; Ma, Y.; Bao, Y.; Liu, Z.L.; Chen, L.; Dai, F.Y.; Li, Z. Electrospun PLGA/SF/artemisinin composite nanofibrous membranes for wound dressing. Int. J. Biol. Macromol. 2021, 183, 68–78. [Google Scholar] [CrossRef]
- Stanic, V.; Pierre, A.C.; Etsell, T.H.; Mikula, R.J. Preparation and characterization of GeS2. J. Mater. Res. 1996, 11, 363–372. [Google Scholar] [CrossRef]
- Dionigi, C.; Posati, T.; Benfenati, V.; Sagnella, A.; Pistone, A.; Bonetti, S.; Ruani, G.; Dinelli, F.; Padeletti, G.; Zamboni, R.; et al. A nanostructured conductive bio-composite of silk fibroin-single walled carbon nanotubes. J. Mater. Chem. B 2014, 2, 1424–1431. [Google Scholar] [CrossRef]
- Zhang, C.C.; Song, D.W.; Lu, Q.; Hu, X.; Kaplan, D.L.; Zhu, H.S. Flexibility Regeneration of Silk Fibroin in Vitro. Biomacromolecules 2012, 13, 2148–2153. [Google Scholar] [CrossRef] [PubMed] [Green Version]
- Khan, M.M.I.R.; Morikawa, H.; Gotoh, Y.; Miura, M.; Ming, Z.; Sato, Y.; Iwasa, M. Structural characteristics and properties of Bombyx mori silk fiber obtained by different artificial forcibly silking speeds. Int. J. Biol. Macromol. 2008, 42, 264–270. [Google Scholar] [CrossRef] [PubMed]
- Lan, D.W.; Liu, Z.L.; Zhou, J.L.; Xu, M.T.; Li, Z.; Dai, F.Y. Preparation and characterization of silk fibroin/polyethylene oxide nanofiber membranes with antibacterial activity. J. Biomed. Mater. Res. Part A 2021, 110, 287–297. [Google Scholar] [CrossRef] [PubMed]
- RuizCardona, L.; Sanzgiri, Y.D.; Benedetti, L.M.; Stella, V.J.; Topp, E.M. Application of benzyl hyaluronate membranes as potential wound dressings: Evaluation of water vapour and gas permeabilities. Biomaterials 1996, 17, 1639–1643. [Google Scholar] [CrossRef]
- Morgado, P.I.; Aguiar-Ricardo, A.; Correia, I.J. Asymmetric membranes as ideal wound dressings: An overview on production methods, structure, properties and performance relationship. J. Membr. Sci. 2015, 490, 139–151. [Google Scholar] [CrossRef]
- Ege, Z.R.; Akan, A.; Oktar, F.N.; Lin, C.C.; Kuruca, D.S.; Karademir, B.; Sahin, Y.M.; Erdemir, G.; Gunduz, O. Indocyanine green based fluorescent polymeric nanoprobes for in vitro imaging. J. Biomed. Mater. Res. Part B Appl. Biomater. 2020, 108, 538–554. [Google Scholar] [CrossRef] [PubMed]
- Engel, E.; Schraml, R.; Maisch, T.; Kobuch, K.; Koenig, B.; Szeimies, R.M.; Hillenkamp, J.; Baumler, W.; Vasold, R. Light-induced decomposition of indocyanine green. Investig. Ophthalmol. Vis. Sci. 2008, 49, 1777–1783. [Google Scholar] [CrossRef] [PubMed]
- Simoes, D.; Miguel, S.P.; Ribeiro, M.P.; Coutinho, P.; Mendonca, A.G.; Correia, I.J. Recent advances on antimicrobial wound dressing: A review. Eur. J. Pharm. Biopharm. 2018, 127, 130–141. [Google Scholar] [CrossRef] [PubMed]
- Boluki, E.; Moradi, M.; Azar, P.S.; Fekrazad, R.; Pourhajibagher, M.; Bahador, A. The effect of antimicrobial photodynamic therapy against virulence genes expression in colistin-resistance Acinetobacter baumannii. Laser Ther. 2019, 28, 27–33. [Google Scholar] [CrossRef] [PubMed]
- de Freitas, M.T.M.; Soares, T.T.; Aragao, M.G.B.; Lima, R.A.; Duarte, S.; Zanin, I.C.J. Effect of Photodynamic Antimicrobial Chemotherapy on Mono- and Multi-Species Cariogenic Biofilms: A Literature Review. Photomed. Laser Surg. 2017, 35, 239–245. [Google Scholar] [CrossRef] [PubMed] [Green Version]
- Li, M.; Chen, J.; Shi, M.T.; Zhang, H.L.; Ma, P.X.; Guo, B.L. Electroactive anti-oxidant polyurethane elastomers with shape memory property as non-adherent wound dressing to enhance wound healing. Chem. Eng. J. 2019, 375, 121999. [Google Scholar] [CrossRef]
- Costa, R.A.; Farah, M.E.; Freymuller, E.; Morales, P.H.; Smith, R.; Cardillo, J.A. Choriocapillaris photodynamic therapy using indocyanine green. Am. J. Ophthalmol. 2001, 132, 557–565. [Google Scholar] [CrossRef]
- Xu, L.H.; Tong, G.H.; Song, Q.L.; Zhu, C.Y.; Zhang, H.L.; Shi, J.J.; Zhang, Z.Z. Enhanced Intracellular Ca2+ Nanogenerator for Tumor-Specific Synergistic Therapy via Disruption of Mitochondrial Ca2+ Homeostasis and Photothermal Therapy. Acs Nano 2018, 12, 6806–6818. [Google Scholar] [CrossRef]

| Sample Name | Concentration of SF wt% | Concentration of PLGA wt% | Concentration of ICG wt% |
|---|---|---|---|
| SF/PLGA | 6.0 | 6.0 | - |
| SF/PLGA/20ICG | 6.0 | 6.0 | 0.2 |
| SF/PLGA3 | 3.0 | 9.0 | - |
| SF/PLGA3/20ICG | 3.0 | 9.0 | 0.2 |
| SF/PLGA5 | 2.0 | 10.0 | - |
| SF/PLGA5/20ICG | 2.0 | 10.0 | 0.2 |
Publisher’s Note: MDPI stays neutral with regard to jurisdictional claims in published maps and institutional affiliations. |
© 2022 by the authors. Licensee MDPI, Basel, Switzerland. This article is an open access article distributed under the terms and conditions of the Creative Commons Attribution (CC BY) license (https://creativecommons.org/licenses/by/4.0/).
Share and Cite
Zhou, J.; Wang, H.; Wu, H.; Lan, D.; Peng, Y.; Li, Z.; Dai, F. Electrospun SF/PLGA/ICG Composite Nanofibrous Membranes for Potential Wound Healing and Tumor Therapy. Processes 2022, 10, 850. https://doi.org/10.3390/pr10050850
Zhou J, Wang H, Wu H, Lan D, Peng Y, Li Z, Dai F. Electrospun SF/PLGA/ICG Composite Nanofibrous Membranes for Potential Wound Healing and Tumor Therapy. Processes. 2022; 10(5):850. https://doi.org/10.3390/pr10050850
Chicago/Turabian StyleZhou, Jiale, Hai Wang, Haiyan Wu, Dongwei Lan, Yan Peng, Zhi Li, and Fangyin Dai. 2022. "Electrospun SF/PLGA/ICG Composite Nanofibrous Membranes for Potential Wound Healing and Tumor Therapy" Processes 10, no. 5: 850. https://doi.org/10.3390/pr10050850
APA StyleZhou, J., Wang, H., Wu, H., Lan, D., Peng, Y., Li, Z., & Dai, F. (2022). Electrospun SF/PLGA/ICG Composite Nanofibrous Membranes for Potential Wound Healing and Tumor Therapy. Processes, 10(5), 850. https://doi.org/10.3390/pr10050850

